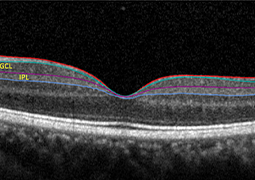

- Choroidální neovaskulární membrána u dětí, dlouhodobé výsledky terapie anti-VEGF preparátem
- Preserflo MicroShunt verzus trabekulektómia: klinické výsledky 6-mesačnej retrospektívnej štúdie
- Metrické příčiny refrakčních vad oka
- Outcomes of Chandelier-Assisted Segmental Scleral Buckling Compared to Conventional Scleral Buckling for Primary Rhegmatogenous Retinal Detachment: A comparative retrospective study
- Postradiačná makulopatia u pacientov s malígnym melanómom corpus ciliare a chorioidey po stereotaktickej rádiochirurgii